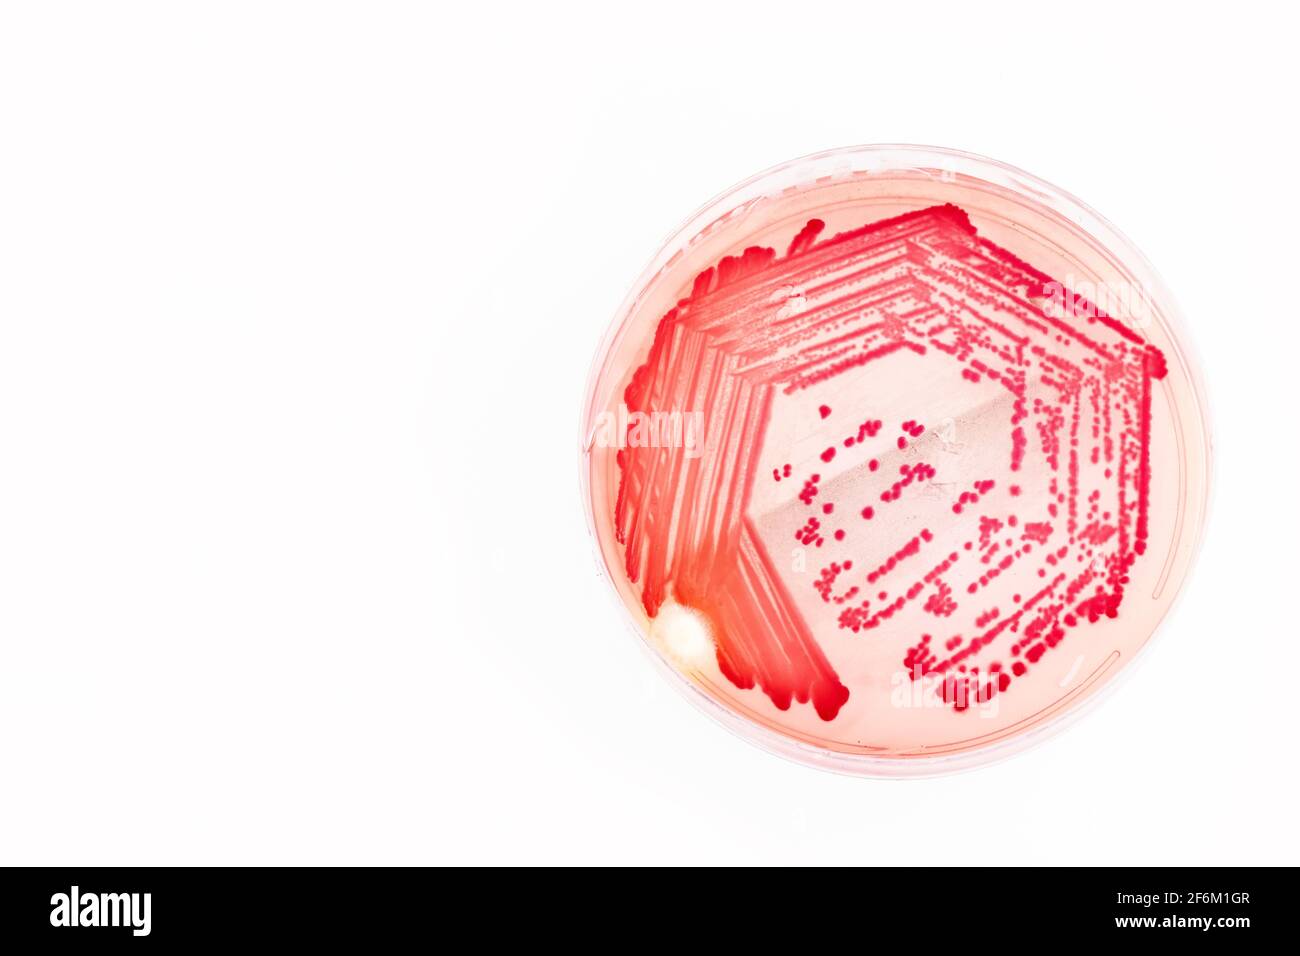
Helicobacter pylori bacteria - Draufsicht Stockfoto

Schnellfilter:
Helicobacter pylori Stockfotos & Bilder

RFJ4YTD6–Helicobacter Pylori im menschlichen Magen betrachtet bei 400 X Vergrößerung mit Giemsa Fleck.

RM2HW37DX–Medizinischer Probenbehälter mit kleinem Messlöffel/Löffel zur Entnahme von Stuhlproben (wird vom britischen Gesundheitsministerium zur Entnahme medizinischer Proben/Proben verwendet).

RMCF211W–Helicobacter Pylori INFAI diagnostischen Testkit, das Kohlenstoff-13 Emissionen misst ausgeatmet in Atem

RF3CXH8EW–Eine 3D-Visualisierung betont die bakterielle HELICOBACTER PYLORI-Infektion im Magen. Primäre Ursache gastrointestinaler Erkrankungen.

RF2H1BFX2–Lublin, Polen. 14. Oktober 2021. Flasche Pylera Kombinationsmedikament - zur Behandlung von Magengeschwüren, die durch Helicobacter pylori-Bakterien verursacht werden

RF2B1P4EC–Abbildung: Helicobacter Pylori-Bakterien auf abstraktem Farbhintergrund. Medizinisches Konzept. 3 D rendern.

RF3D3F0K0–Mikrobiom und Darmmikrobiota Gute und schlechte Bakterien im Magen als probiotisches Bakterium im Körper als verdauungsfördernde Mikroflora im Dickdarm oder bowe

RFJ65JHH–Verdauungs-Geschwür und Helicobacter Pylori Infografik mit Symptomen und Ursachen, Magen Kreuz Abschnitt Diagramm, medizinische illustration

RF2R38BBM–Prag, Tschechische republik – Mai 23 2023 : Apotheke- Klacid Antibiotika Medizin in Pillenform in einer Box auf einem Tisch mit weichem Fokus Hintergrund.

RM2HW37E5–Medizinischer Probenbehälter mit kleinem Messlöffel/Löffel zur Entnahme von Stuhlproben (wird vom britischen Gesundheitsministerium zur Entnahme medizinischer Proben/Proben verwendet).

RMCF211A–Helicobacter Pylori INFAI diagnostischen Testkit, das Kohlenstoff-13 Emissionen misst ausgeatmet in Atem

RF2JKCRAC–3D Bild der Skelettformel von Omeprazol - molekularchemische Struktur von Medikamenten zur gastroösophagealen Refluxkrankheit, isoliert auf weißem Hintergrund

RF2FK0KY5–Probiotika und Antibiotika-Pillen . Behandlung von Helicobacter pylori . Drogen auf blauem Hintergrund

RF2GBBNKG–Helicobacter pylori Vacuolating Cytotoxin A oligomere Assembly 2a. 3D-Gaußsche Oberflächenmodell in zwei purpedikulären Projektionen, Farbschema für Ketten-id

RFE81AY9–Konzeptbild von Helicobacter. Helicobacter ist eine Gattung Gram-negativen Bakterien besitzen eine charakteristische Helixform.

RF2RBE4DN–Medizinisches Stethoskop, Notizbuch und Beschriftung auf Holzblöcken Helicobacter pylori, Bakterien vermehren sich im Magen

RMBM0MM9–Allgemeines Bild der Kapsel, Kasten und Paket von Omeprazol Gastro resistenten Kapseln zur Behandlung von Sodbrennen und Magen-Säure

RF2R38A8A–Prag, Tschechische republik – Mai 23 2023 : Apotheke- Klacid Antibiotika Medizin in Pillenform in einer Box auf einem Tisch mit weichem Fokus Hintergrund.

RMCF2124–Helicobacter Pylori INFAI diagnostischen Testkit, das Kohlenstoff-13 Emissionen misst ausgeatmet in Atem

RFWAB1B7–Männliche Büroangestellter holding Magen Magen, Gastritis, Magengeschwür, Helicobacter Pylori, Speiseröhrenkrebs diverticulums

RF2E264KA–Irvine, Schottland, Großbritannien - 09. Januar 2021: Peppermint Liquid der Marke Peptac von MA Pinewood Laboratories in zwei 500ml recycelbaren Glasflaschen und Label g

RM2R88FFW–Tabletten OMEP, Clarithromycin, Metronidazol AL 400, Behandlung von Helicobacter pylori, befreit, Objekt

RFJ65HTP–Helicobacter Pylori Infektion Magen, wodurch Schleimhaut Schaden und Magengeschwür, medizinische illustration

RF3D3F0KP–Helicobacter pylori-Bakterien im Mikroskop mit Mageninfektion und mikrobiologischem Forschungskonzept für Gesundheit und Verdauungskrankheiten.

RFHPR09A–Helicobacter Pylori ist ein gramnegatives, mikroaerophil Bakterium im Magen gefunden. 3D illustration

RF2AJXAXB–3D-Abbildung: Mikroskopische Ansicht eines einzelnen helicobacter Pylori Bakterium im Magen

RF2R38AE8–Prag, Tschechische republik – Mai 23 2023 : Apotheke- Klacid Antibiotika Medizin in Pillenform in einer Box auf einem Tisch mit weichem Fokus Hintergrund.

RF3BH5JMM–Helicobacter pylori. Magenbakterium. Untersucht auf seine Rolle bei Magengeschwüren und Krebs.

RMCF212M–Helicobacter Pylori INFAI diagnostischen Testkit, das Kohlenstoff-13 Emissionen misst ausgeatmet in Atem

RF2NH7F1A–Vektordarstellung eines Helicobacter pylori-Bakteriums im Cartoon-Stil, isoliert auf weißem Hintergrund

RF2GY2K2E–Gruppe von Bakterien wie Escherichia coli, Helicobacter pylori oder Salmonellen 3D-Darstellung. Mikrobiologie, Medizin, Bakteriologie, Biologie,

RF2HGA1YN–Helicobacter pylori-Bakterien. Magen mit Magengeschwüren und Vergrößerungsglas. Vektorgrafik

RF2WCXBMB–Helicobacter pylori ist ein gramnegatives, flagelliertes, helikales Bakterium. Es ist in der Lage, die Magenschleimhaut zu besiedeln. 3D-Rendering

RFRY7CX4–Asiatische junge Männer leiden unter Magengeschwüren. Gastritis durch die Infektion mit H. pylori-Bakterien im Gesundheitswesen und Gesundheit Problem Konzept verursacht

RF2H5T56W–Die Darstellung von Helicobacter pylori zeigt ein Holzmodell, das schweres Gewicht ausdrückt, um Kampf und Schmerz im Umgang mit Helicobacter pylori, 3d il, zu symbolisieren

RF3CXH81X–Eine 3D-Visualisierung betont die bakterielle HELICOBACTER PYLORI-Infektion im Magen. Primäre Ursache gastrointestinaler Erkrankungen.

RF2R38C3T–Prag, Tschechische republik – Mai 23 2023 : Apotheke- Klacid Antibiotika Medizin in Pillenform in einer Box auf einem Tisch mit weichem Fokus Hintergrund.

RF2YCF5MF–Helicobacter pylori-Vektorillustration. Handgezogener Magen, Bakterien. Helles, informatives medizinisches Bild. Erkrankungen des Magens, Zwölffingerdarms, Osophagus

RFFEG1CM–Helicobacter Pylori Bakterium, Computer Bild. H. Pylori ist ein gramnegatives bewegliche Bakterium, das zugeordnet ist

RMCF211M–Helicobacter Pylori INFAI diagnostischen Testkit, das Kohlenstoff-13 Emissionen misst ausgeatmet in Atem

RF2B1P49P–Helicobacter Pylori Bakterium mit hohen Details isoliert auf schwarzem Hintergrund. 3D-Rendering.

RFJ65JER–Verdauungs-Geschwür und Helicobacter Pylori Infografik mit Symptomen und Ursachen, Magen Kreuz Abschnitt Diagramm, medizinische illustration

RF2T47FKT–Querschnitt eines menschlichen Magens mit Ulzera. Nahaufnahme von Bakterien Helicobacter pylori, die Magengeschwüre verursachen. Peptische Ulzera. Vektorabbildung

RF2WCN4G3–Helicobacter pylori ist ein gramnegatives, flagelliertes, helikales Bakterium. Es ist in der Lage, die Magenschleimhaut zu besiedeln. 3D-Rendering

RF2CT62C0–Helicobacter Pylori ist ein gramnegatives, mikroaerophil Bakterium im Magen gefunden. 3D illustration

RF2FK0KYA–Weiße Probiotische Kapseln . Eine rote und weiße Kapsel zwischen weißen Kapseln . Drogen auf blauem Hintergrund . Pillen in einer Reihe

RFRY7DPF–Asiatische junge Männer leiden unter Magengeschwüren. Gastritis durch die Infektion mit H. pylori-Bakterien im Gesundheitswesen und Gesundheit Problem Konzept verursacht

RF2H5RFJ1–Die Auswirkungen von Helicobacter pylori und der soziale Einfluss werden als Pranger dargestellt, um die Auswirkungen von Helicobacter pylori auf die menschliche Gesundheit und seinen Signifikan darzustellen

RF3CXH8E8–Eine 3D-Visualisierung betont die bakterielle HELICOBACTER PYLORI-Infektion im Magen. Primäre Ursache gastrointestinaler Erkrankungen.